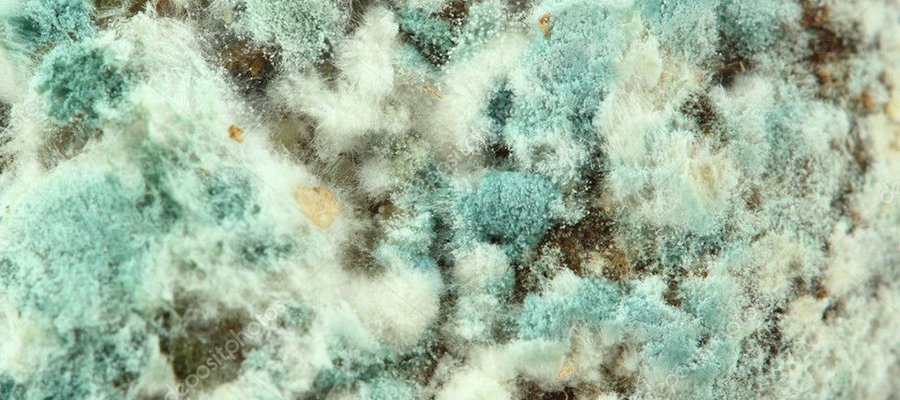

Küf Mantarı Alerjisi Nedir?
Küf Mantarı Alerjisi, olduğunuzu düşünüyorsanız küf sporlarını soluduğunuzda bağışıklık sisteminiz aşırı tepki verir. Hava nemli olduğunda veya yüksek küf konsantrasyonuna sahip iç veya dış mekanlardaysanız belirtileri fark edebilirsiniz.
Bazı insanlarda küf mantarı alerjisi astımla bağlantılıdır ve maruz kalma solunum problemlerine ve diğer solunum semptomlarına neden olur. Küf mantarı alerjisi kişide varsa, tepkinizi tetikleyen küfün türü ne olursa olsun, en iyi savunmanız maruziyetinizi azaltmaktır. İlaçlar küfe karşı alerjik reaksiyonları kontrol etmeye yardımcı olabilir.
Küf Mantarı Alerjisi Belirtileri
Küf mantarı alerjisi, diğer üst solunum yolu alerjileri türleriyle aynı semptomlara ve belirtilere neden olur. Küf mantarı alerjisinin sebep olduğu alerjik rinit semptomları ve belirtileri şunları içerir:
- Hapşırmak,
- Burun akıntısı,
- Öksürük ve postnazal damlama,
- Kaşıntılı gözler, burun ve boğazda yanma,
- Sulu gözler,
- Kuru ve pullu cilt
Küf mantarı alerjisi belirtileri kişiden kişiye değişir ve hafiften şiddetliye kadar da değişebilir. Yıl boyunca veya yalnızca belirli zamanlarda semptomlarınız olabilir.
Küf Mantarı Alerjisinde Risk Faktörleri
Küf mantarı alerjisi geliştirmeyi veya küf alerjisi semptomlarını kötüleştirmeyi mümkün kılan bazı faktörler şunlardır:
- Ailede küf mantarı alerjisi olan kişilerin olması: Ailenizde alerjisi ve astımı olanlar varsa, küfe alerjiniz olma olasılığı daha yüksektir.
- Sizi küflenmeye maruz bırakan bir işe sahip olmak: Küfe en çok maruz kalan meslekler arasında tarım, süt ürünleri hazırlama, tomrukçuluk, fırıncılık, değirmencilik, marangozluk, seralar, üzüm bağları ve mobilya tamiri yer alır.
- Nem oranı yüksek bir evde yaşamak: Evinizin içindeki nem oranı yüzde 50’nin üzerindeyse küf oluşumu daha olasıdır.
- Koşullar uygun olduğunda, küf hemen her yerde büyüyebilir: Bodrumlarda, duvarların arkasındaki çerçevelerde, sabunlu fayans derzlerinde ve diğer nemli yüzeylerde ve kilimlerin altında bulunabilir. Yüksek düzeyde ev küfüne maruz kalmak, küf alerjisi semptomlarına neden olabilir.
- Yüksek neme maruz kalan bir binada çalışmak veya yaşama durumu: Örnekler arasında sızdıran borular, yağmur yağdığında sızan su ve sel hasarı sayılabilir. Bir noktada, hemen hemen her bina bir tür neme maruz kalır ve bu nem küfün büyümesine izin verir.
- Havasız bir evde yaşamak: İyi yalıtılmış pencere ve kapılar, nemi içeride hapsedebilir ve uygun havalandırmayı engelleyebilir, böylece küf oluşumu için en uygun koşulları yaratır. Banyo, mutfak ve bodrum gibi nemli ortamlar en savunmasız olan yerlerdir.
Küf mantarından korunmak için aşağıdakileri yapmanız gerekir:
- Nem oranı yüksek ortamlarda bulunmayın.
- Odaları her gün havalandırın. Özellikle ıslak, kapalı veya karanlıksa havalandırma önemlidir.
- Çocuk odalarında güneş almalı ve nem olmamalıdır.
- Banyo veya duştan sonra, nemin dışarı çıkması için pencereyi açın.
- Mutfağı ve banyoyu çamaşır suyuyla temizleyin.
- Klima filtrelerini temizleyin.
- Nemlendirici kullanmayın.
- Evde bitki bulundurmayın. Özellikle onları çok sulamanız gerekiyorsa bitkiler küf mantarı alerjisi oluşumuna sebep olabilir.
Küf Mantarı Alerjisinin Neden Olabileceği Durumlar
Küfe karşı alerjik reaksiyonların çoğu, kendinizi gerçekten kötü hissetmenize neden olabilecek nezle benzeri semptomlar içerir, ancak bunlar ciddi değildir. Küf mantarı alerjisi öksürüğe, gözlerde kaşıntıya ve sizi çok rahatsız hissettirebilecek diğer semptomlara neden olabilir. Bununla birlikte, küfün neden olduğu bazı alerjik durumlar daha ciddidir. Bunlar şunları içerir:
- Astım, küf alerjiniz ve astımınız varsa, şiddetli bir astım krizi geçirmeniz durumunda bir acil durum planınız olduğundan emin olun.
- Alerjik mantar sinüziti: Bunun nedeni sinüslerdeki mantara karşı inflamatuar bir reaksiyondur.
- Alerjik bronkopulmoner aspergilloz: Akciğerlerdeki mantarlara karşı bu reaksiyon, astımlı veya kistik fibrozlu kişilerde ortaya çıkabilir.
- Aşırı duyarlılık pnömonisi: Bu durum, küf sporları benzeri havadaki toz ve partiküllere maruz olunduğunda akciğerlerde iltihaplanmaya neden olduğunda ortaya çıkar. Alerjiye neden olan toza mesleki maruziyetten kaynaklanabilir.
Duyarlı kişilerde küf, alerjenlere ek olarak başka sağlık riskleri de oluşturabilir. Örneğin küf, cilt veya mukozal enfeksiyonlara neden olabilir. Bununla birlikte, HIV, AIDS hastaları veya bağışıklık sistemini baskılayan ilaçlar ve alanlar gibi bağışıklık sistemi zayıf olan kişiler dışında, küf genellikle sistemik enfeksiyonlara neden olmaz.
Küflerden Korunma Yöntemleri
Neye alerjiniz olduğunu öğrenmek için kan testi veya cilt testi yaptırabilirsiniz. Bu yöntem, diğer alerji türlerini (polenlere, akarlara, hayvanlar gibi) bulmakla aynıdır. Tedavi sırasında evinizdeki küfü azaltmak için bazı ipuçlarını göz önünde bulundurabilirsiniz. Bunlar:
- Kaçınmak daha iyidir. Birçok mantarın olabileceği yerde bulunmamak gerekir.
- Astım için kullanılan ilaçlardan yararlanılabilir.
- Alerji aşısı (immünoterapi) yapılabilir.
- Nemli ortamlardan kaçının.
- Özellikle nemli veya kapalı odaları iyi havalandırın.
- Mutfağı ve banyoyu çamaşır suyuyla temizleyin.
- Nemli lekeleri çıkarın.
- Klima filtrelerini periyodik olarak temizleyin.
- Nemlendiriciler kullanmayın.
Küf mantarı alerjisi korunma yöntemi olarak sıhhi tesisat sızıntıları veya yeraltı suyu sızıntıları gibi bodrumlardaki nem kaynaklarını ortadan kaldırabilirsiniz. Evinizin herhangi bir yerinde küf kokulu bir nem alma cihazı kullanın. Nem seviyesini yüzde 50’nin altında tutun. Toplama kabını ve yoğuşmalı serpantinleri düzenli olarak temizlemeyi unutmayın.
Bir klima kullanın ve yüksek verimli hava filtresine (HEPA) sahip bir merkezi klima kurmayı düşünün. Bu filtre türü, küf sporlarını evinizin içinde dolaşmadan önce dışarıdaki havadan yakalayabilir. Kalorifer ve klimalarınızın filtrelerini düzenli olarak değiştirin. Yetkililerin ısıtma kanallarını kontrol etmelerini ve gerekirse temizlemelerini isteyin.
Tüm banyoların iyi havalandırıldığından emin olun ve havayı kurutmak için duş veya banyo sırasında ve hemen sonrasında fanı çalıştırın. Banyoda vantilatör yoksa duş alırken veya banyo yaparken pencereyi veya kapıyı açın. Banyo ve bodrum katlarına kilim koymayın.
Ev temelinizin etrafındaki yaprakları ve bitki örtüsünü düzenli olarak kaldırarak ve olukları temizleyerek yeraltı suyunu evinizden tahliye etmeyi daha da kolaylaştırın. Eski kitaplardan ve gazetelerden kurtulun veya geri dönüştürün. Bodrum gibi nemli yerlerde bırakılırsa çabucak küflenebilirler.
Küf Mantarı Alerji Tedavi Fiyatları 2026
Küf mantarı alerjisi fiyatları için doktorunuzdan bilgi alabilirsiniz. Ayrıca küf alerjiniz ve astımınız varsa küf sporlarına maruz kalmak astım semptomlarınızı tetikleyebilir. Bazı insanlarda, belirli küf türlerine maruz kalmak ciddi bir astım atağını tetikleyebilir. Astım belirtileri ve semptomları şunları içerir:
- Öksürük,
- Nefes alırken hırıltı,
- Nefes darlığı,
- Göğüs basıncı.
Burun tıkanıklığı, hapşırma, sulanma, nefes darlığı, hırıltılı solunum veya geçmeyen diğer rahatsız edici semptomlarınız varsa doktorunuza görünün.
Herhangi bir alerjide olduğu gibi, aşırı duyarlı bir bağışıklık sistemi yanıtı, küf alerjisi semptomlarını tetikler. Vücut, havadaki küçük küf sporlarını soluyarak onları istilacı olarak tanır ve onlarla savaşmak için alerjiye neden olan antikorlar üretir.
Maruz kalma sona erdiğinde, vücut bu istilacıyı “hatırlayan” antikorlar üretmeye devam eder, bu nedenle küfle daha fazla temas, bir bağışıklık sistemi tepkisini tetikler. Bu reaksiyon, kaşıntılı, sulu gözlere, hapşırmaya, burun akıntısına ve başka küf alerjisi belirtilerine neden olan histamin gibi maddelerin salınımını tetikler.
Küf hem iç hem de dış ortamlarda çok yaygındır. Birçok küf türü vardır, fakat sadece belirli küf türleri alerjiye sebep olur. Bir küf türüne alerjiniz olması, mutlaka başka bir türe alerjiniz olacağı anlamına gelmez.
En yaygın alerjiye neden olan küflerden bazıları Alternaria, Cladosporium, Aspergillus ve Penicillium’dur. Küf mantarı alerjisi teşhisi için tedaviler büyük fayda sağlar. Küf Mantarı Alerjisi Tedavi Fiyatları 2026 hakkında bilgi almak için bizlere ulaşabilirsiniz.


